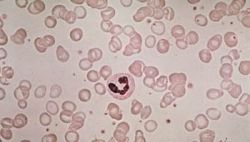

Во сколько лет у девочек начинаются месячные. Возможные проблемы
Первая менструация у девушки - это всегда неизвестность и замешательство. Однако существует целый ряд внешних и внутренних признаков, свидетельствующих о взрослении организма.
Татьяна Рудакова